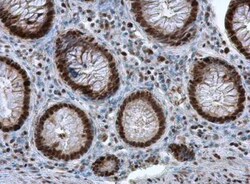
PCNA Antibody, Novus Biologicals 0.1mL; Unlabeled:Anticuerpos

missing translation for 'onlineSavingsMsg'
Learn More
Learn More
PCNA Antibody, Novus Biologicals™
Rabbit Polyclonal Antibody
Marca: Novus Biologicals NBP1-32075
Este artículo no se puede devolver.
Vea la política de devoluciones
Descripción
PCNA Polyclonal specifically detects PCNA in Human, Mouse, Rat, Golden Syrian Hamster samples. It is validated for Western Blot, Immunohistochemistry, Immunocytochemistry/Immunofluorescence, Immunoprecipitation, Immunohistochemistry-Paraffin, Immunohistochemistry-Frozen.
Especificaciones
| PCNA | |
| Polyclonal | |
| Unconjugated | |
| PBS, 1% BSA, 20% Glycerol (pH7) with 0.025% Proclin 300 | |
| PCNA | |
| Recombinant protein encompassing a sequence within the center region of human PCNA. The exact sequence is proprietary. | |
| Affinity Purified | |
| RUO | |
| Primary | |
| Tested in human and mouse. Predicted cross-reactivity based on sequence identity: Rhesus Monkey (100%). Not yet tested in any other species. | |
| Aliquot and store at -20C or -80C. Avoid freeze-thaw cycles. |
| Western Blot, Immunohistochemistry, Immunocytochemistry, Immunofluorescence, Immunoprecipitation, Immunohistochemistry (Paraffin) | |
| 0.14mg/mL | |
| Western Blot 1:500-1:3000, Immunohistochemistry 1:100-1:1000, Immunocytochemistry/Immunofluorescence 1:100-1:1000, Immunoprecipitation 1:100-1:500, Immunohistochemistry-Paraffin 1:100-1:1000, Immunohistochemistry-Frozen 1:10 - 1:500, In-situ Hybridization | |
| cyclin, DNA polymerase delta auxiliary protein, MGC8367, proliferating cell nuclear antigen | |
| Rabbit | |
| 29 kDa | |
| 0.1 mL | |
| Autophagy, Base Excision Repair, Cell Cycle and Replication, Cellular Markers, Core ESC Like Genes, DNA Polymerases, DNA Repair, Stem Cell Markers | |
| 5111 | |
| Human, Mouse, Rat | |
| IgG |
Corrección del contenido de un producto
Proporcione sus comentarios sobre el contenido del producto rellenando el siguiente formulario.
Título del producto
For Research Use Only
¿Detecta una oportunidad de mejora?Comparta una corrección de contenido